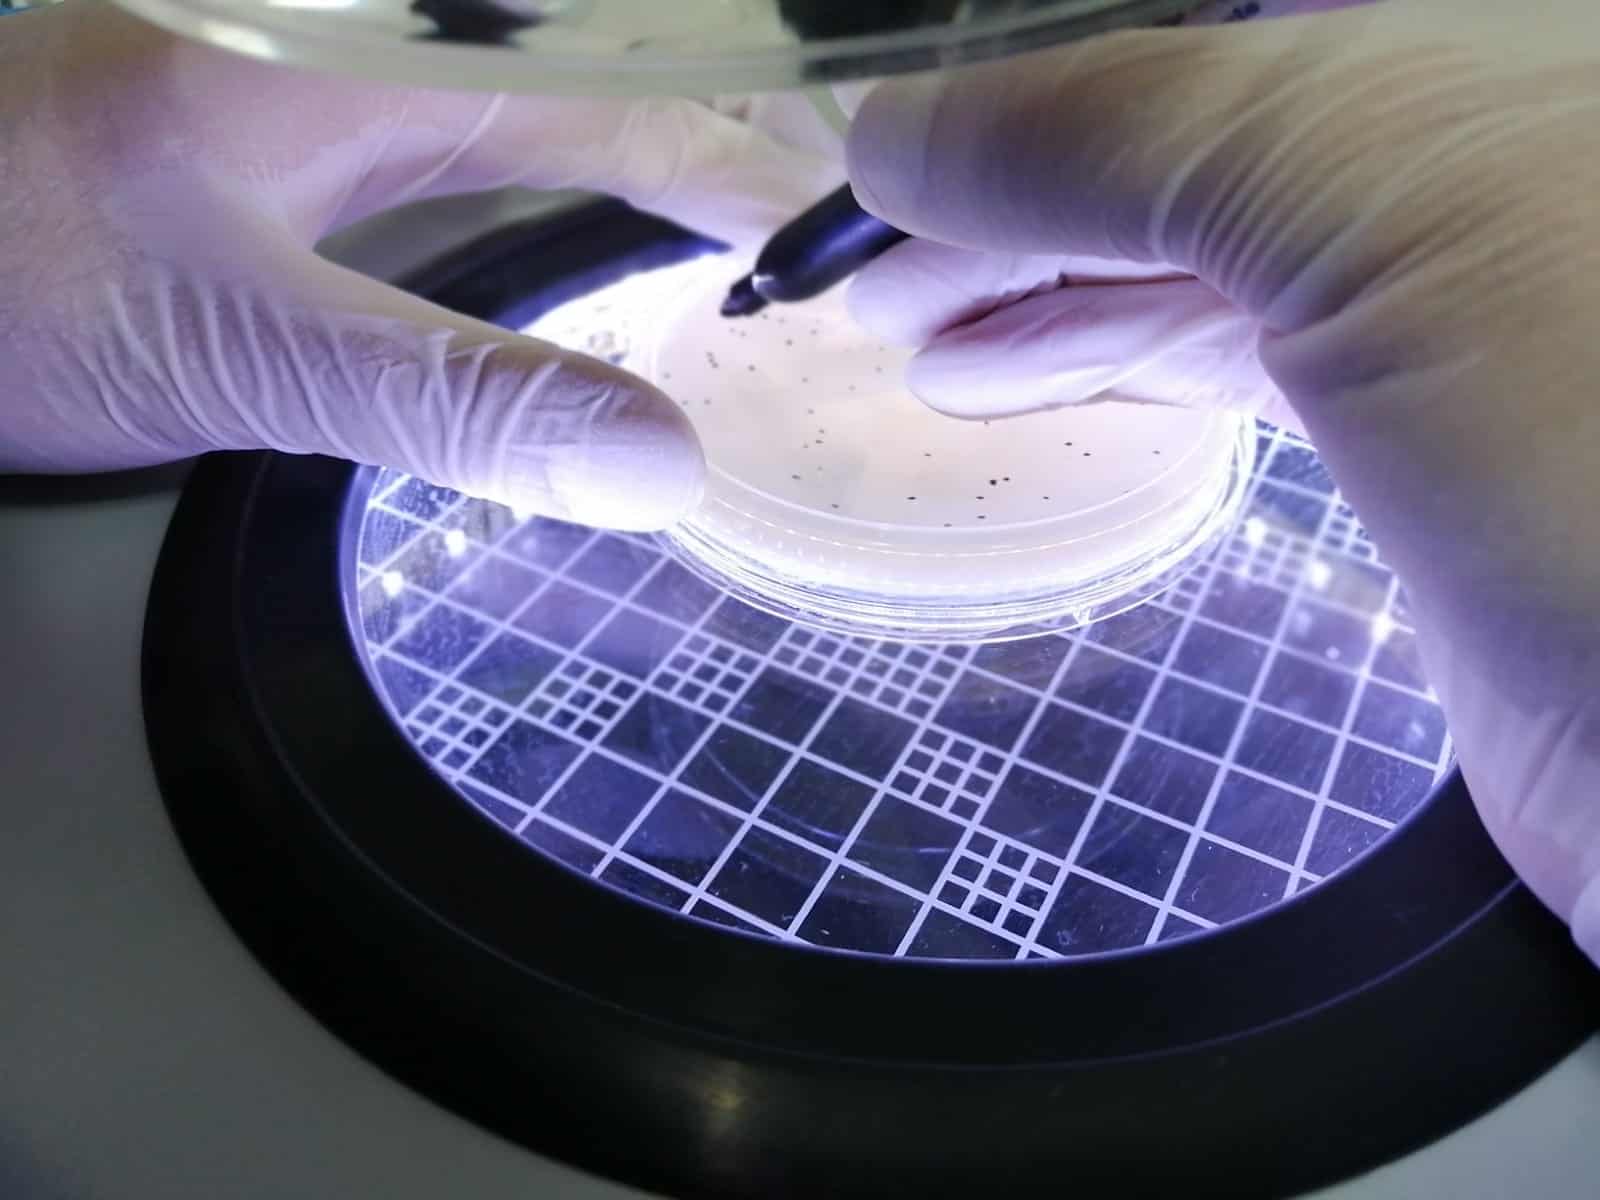

Analisis microbiano de agua para alimentos y bebidas
-
Disponibilidad de Analisis microbiano de agua para alimentos y bebidas :En stock
-
Mínimo de venta de Analisis microbiano de agua para alimentos y bebidas :2 productos a analizar
-
Unidad de Analisis microbiano de agua para alimentos y bebidas :Servicio
-
Tiempo de entrega de Analisis microbiano de agua para alimentos y bebidas :Entrega de resultados 10 días aproximadamente
Descripción de Analisis microbiano de agua para alimentos y bebidas :
Muestreo y Análisis Microbiológico en alimentos, aguas potables, frotis de superficies vivas e inertes, de acuerdo a las normas oficiales mexicanas NOM-092-SSA1-1994, NOM-111-SSA1-1994, entre otras,
Muestreo y Análisis Microbiológico en alimentos, aguas potables, frotis de superficies vivas e inertes, de acuerdo a las normas oficiales mexicanas NOM-092-SSA1-1994, NOM-111-SSA1-1994, entre otras,
Otros productos que vende LV Laboratorios Clínicos

Min. 1



Min. 1



Min. 1



Min. 1



Min. 1



Min. 1


¿Necesitas una cotización personalizada?
Nuestro equipo técnico puede ayudarte a seleccionar Analisis microbiano de agua para alimentos y bebidas ideal según tu línea de producción, velocidad y tipo de material.